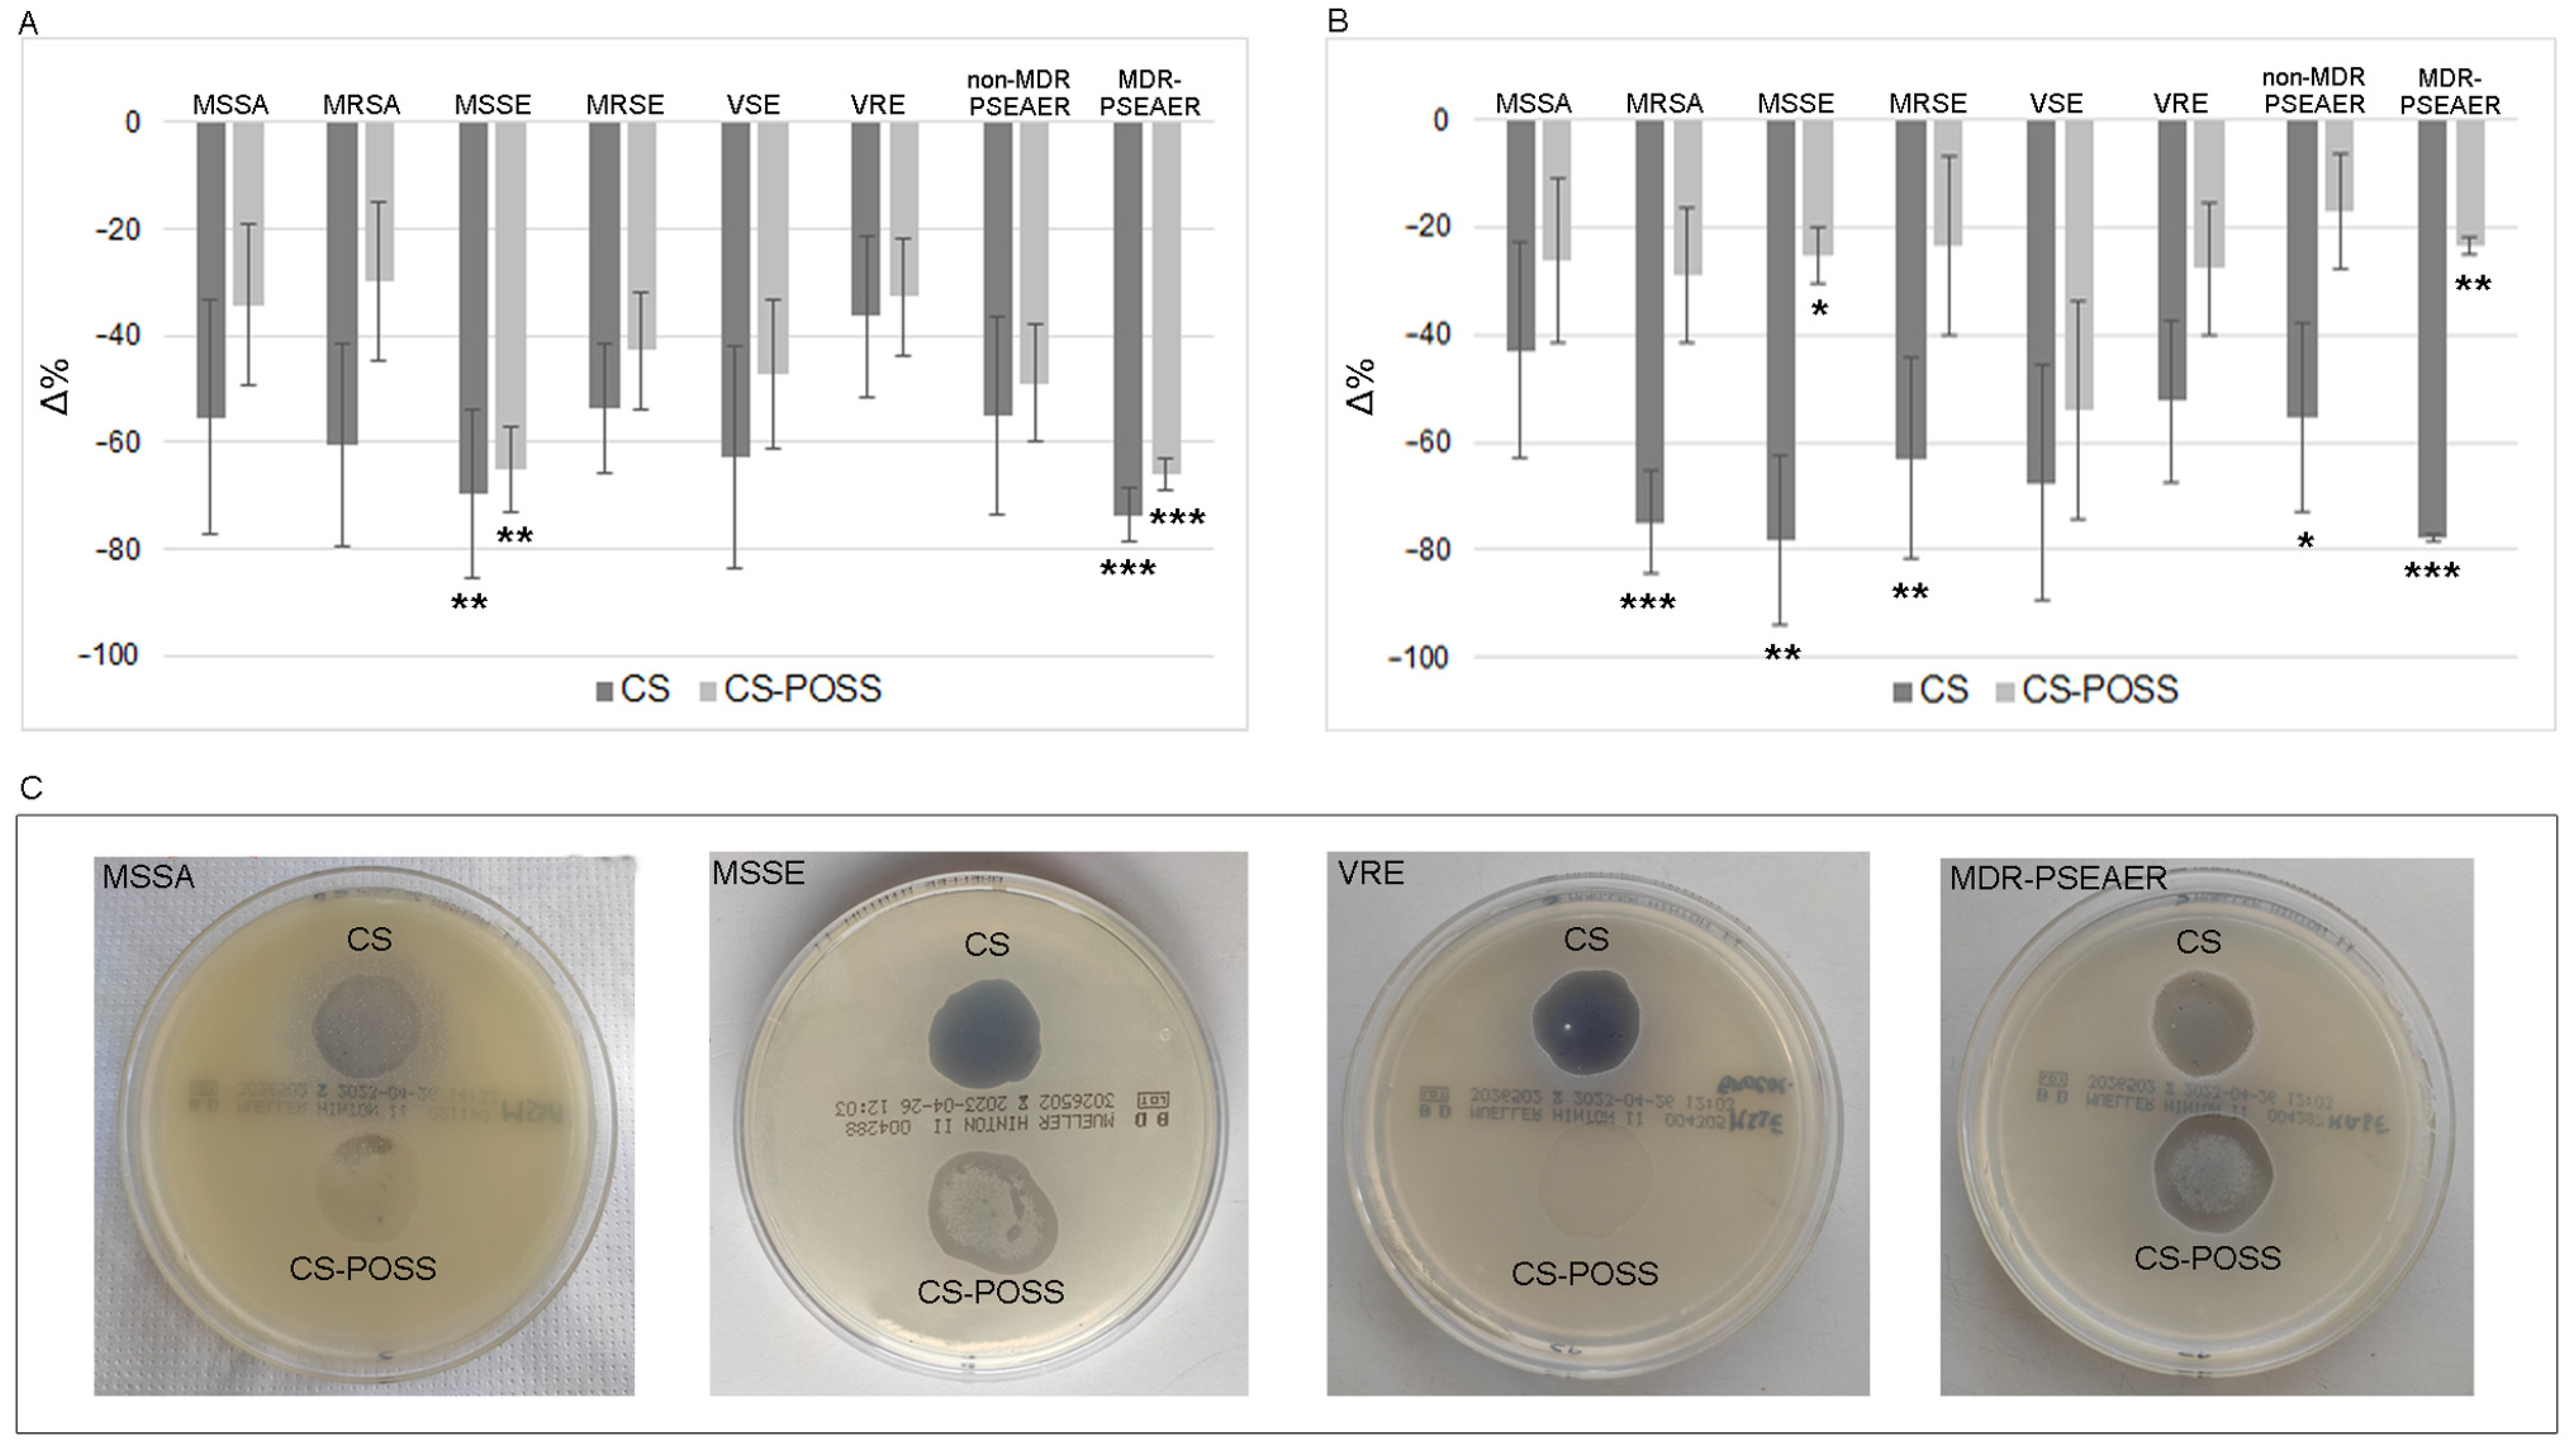
Jfb 14 00428 g001

Promising Materials in the Fight against Healthcare-Associated Infections: Antibacterial Properties of Chitosan-Polyhedral Oligomeric Silsesquioxanes Hybrid Hydrogels
Abstract
:1. Introduction
2. Materials and Methods
2.1. Synthesis of CS-POSS Hybrids
2.2. Synthesis of CS and CS-POSS Hybrid Hydrogels
2.3. Bacterial Strains
2.4. Antimicrobial Activity of CS and CS-POSS
2.5. PI Assay to Monitor Microbial Membrane Permeability
2.6. Bacterial Cell-Surface Properties
2.7. Confocal Microscopic Observation of Biofilm
2.8. Statistical Analyses
3. Results
3.1. Antibiotic Susceptibility of the Tested Strains
3.2. Antibacterial Properties of CS and CS-POSS
3.3. Antibacterial Mechanism
3.4. Inhibitory Properties of CS and CS-POSS towards Biofilm Formation
4. Discussion
5. Conclusions
Author Contributions
Funding
Data Availability Statement
Acknowledgments
Conflicts of Interest
References
- Stewart, S.; Robertson, C.; Pan, J.; Kennedy, S.; Dancer, S.; Haahr, L.; Manoukian, S.; Mason, H.; Kavanagh, K.; Cook, B.; et al. Epidemiology of healthcare-associated infection reported from a hospital-wide incidence study: Considerations for infection prevention and control planning. J. Hosp. Infect. 2021, 114, 10–22. [Google Scholar] [CrossRef]
- Istituto Superiore di Sanità. Infezioni Correlate All’assistenza. Aspetti Epidemilogici. Available online: https://www.epicentro.iss.it/infezioni-correlate/epidemiologia (accessed on 20 June 2023).
- Correa-Martinez, C.L.; Tönnies, H.; Froböse, N.J.; Mellmann, A.; Kampmeier, S. Transmission of Vancomycin-Resistant Enterococci in the Hospital Setting: Uncovering the Patient-Environment Interplay. Microorganisms 2020, 8, 203. [Google Scholar] [CrossRef] [PubMed]
- Behzadi, P.; Baráth, Z.; Gajdács, M. It’s Not Easy Being Green: A Narrative Review on the Microbiology, Virulence and Therapeutic Prospects of Multidrug-Resistant Pseudomonas aeruginosa. Antibiotics 2021, 10, 42. [Google Scholar] [CrossRef]
- Mitevska, E.; Wong, B.; Surewaard, B.; Jenne, C. The Prevalence, Risk, and Management of Methicillin-Resistant Staphylococcus aureus Infection in Diverse Populations across Canada: A Systematic Review. Pathogens 2021, 10, 393. [Google Scholar] [CrossRef]
- Otter, J.A.; Yezli, S.; French, G.L. The role played by contaminated surfaces in the transmission of nosocomial pathogens. Infect. Control Hosp. Epidemiol. 2011, 32, 687–699. [Google Scholar] [CrossRef]
- Facciolà, A.; Pellicanò, G.F.; Visalli, G.; Paolucci, I.A.; Venanzi Rullo, E.; Ceccarelli, M.; D’Aleo, F.; Di Pietro, A.; Squeri, R.; Nunnari, G.; et al. The role of the hospital environment in the healthcare-associated infections: A general review of the literature. Eur. Rev. Med. Pharmacol. Sci. 2019, 23, 1266–1278. [Google Scholar]
- Percival, S.L.; Suleman, L.; Vuotto, C.; Donelli, G. Healthcare-associated infections, medical devices and biofilms: Risk, tolerance and control. J. Med. Microbiol. 2015, 64, 323–334. [Google Scholar] [CrossRef]
- Cristina, M.L.; Spagnolo, A.M.; Orlando, P.; Perdelli, F. The role of the environment in the spread of emerging pathogens in at-risk hospital wards. Rev. Med. Microbiol. 2013, 24, 104–112. [Google Scholar] [CrossRef]
- McHugh, S.M.; Hill, A.D.; Humphreys, H. Laminar airflow and the prevention of surgical site infection. More harm than good? Surgeon 2015, 13, 52–58. [Google Scholar] [CrossRef]
- Morris, A.M.; Gollish, J. Arthroplasty and postoperative antimicrobial prophylaxis. Can. Med. Assoc. J. 2016, 188, 243–244. [Google Scholar] [CrossRef]
- Huttunen, R.; Karppelin, M.; Syrjänen, J. Obesity and nosocomial infections. J. Hosp. Infect. 2013, 85, 8–16. [Google Scholar] [CrossRef]
- Paudel, S.; John, P.P.; Poorbaghi, S.L.; Randis, T.M.; Kulkarni, R. Systematic Review of Literature Examining Bacterial Urinary Tract Infections in Diabetes. J. Diabetes Res. 2022, 2022, 3588297. [Google Scholar] [CrossRef] [PubMed]
- Veerachamy, S.; Yarlagadda, T.; Manivasagam, G.; Yarlagadda, P.K. Bacterial adherence and biofilm formation on medical implants: A review. Proc. Inst. Mech. Eng. Part H J. Eng. Med. 2014, 228, 1083–1099. [Google Scholar] [CrossRef] [PubMed]
- Wolcott, R. Biofilm and catheter-related bloodstream infections. Br. J. Nurs. 2021, 30, S4–S9. [Google Scholar] [CrossRef] [PubMed]
- Ferreres, G.; Ivanova, K.; Ivanov, I.; Tzanov, T. Nanomaterials and Coatings for Managing Antibiotic-Resistant Biofilms. Antibiotics 2023, 12, 310. [Google Scholar] [CrossRef]
- Laganà, A.; Visalli, G.; Corpina, F.; Ferlazzo, M.; Di Pietro, A.; Facciolà, A. Antibacterial activity of nanoparticles and nanomaterials: A possible weapon in the fight against healthcare-associated infections. Eur. Rev. Med. Pharmacol. Sci. 2023, 27, 3645–3663. [Google Scholar] [PubMed]
- Kolahalam, L.A.; Viswanath, I.V.K.; Diwakar, B.S.; Govindh, B.; Reddy, V.; Murthy, Y.L.N. Review on nanomaterials: Synthesis and applications. Mater. Today Proc. 2019, 18, 2182–2190. [Google Scholar] [CrossRef]
- Pan, K.; Zhong, Q. Organic nanoparticles in foods: Fabrication, characterization, and utilization. Annu. Rev. Food Sci. Technol. 2016, 7, 245–266. [Google Scholar] [CrossRef]
- Idrees, H.; Zaidi, S.Z.J.; Sabir, A.; Khan, R.U.; Zhang, X.; Hassan, S.U. A Review of Biodegradable Natural Polymer-Based Nanoparticles for Drug Delivery Applications. Nanomaterials 2020, 10, 1970. [Google Scholar] [CrossRef]
- Bharathiraja, S.; Bui, N.Q.; Manivasagan, P.; Moorthy, M.S.; Mondal, S.; Seo, H.; Phuoc, N.T.; Vy Phan, T.T.; Kim, H.; Lee, K.D.; et al. Multimodal tumor-homing chitosan oligosaccharide-coated biocompatible palladium nanoparticles for photo-based imaging and therapy. Sci. Rep. 2018, 8, 500. [Google Scholar] [CrossRef]
- Ferreres, G.; Ivanova, K.; Torrent-Burgués, J.; Tzanov, T. Multimodal silver-chitosan-acylase nanoparticles inhibit bacterial growth and biofilm formation by Gram-negative Pseudomonas aeruginosa bacterium. J. Colloid Interface Sci. 2023, 646, 576–586. [Google Scholar] [CrossRef] [PubMed]
- Thirupathi, K.; Raorane, C.J.; Ramkumar, V.; Ulagesan, S.; Santhamoorthy, M.; Raj, V.; Krishnakumar, G.S.; Phan, T.T.V.; Kim, S.C. Update on Chitosan-Based Hydrogels: Preparation, Characterization, and Its Antimicrobial and Antibiofilm Applications. Gels 2023, 9, 35. [Google Scholar] [CrossRef] [PubMed]
- Zhang, L.; Ma, Y.; Pan, X.; Chen, S.; Zhuang, H.; Wang, S. A composite hydrogel of chitosan/heparin/poly (γ-glutamic acid) loaded with superoxide dismutase for wound healing. Carbohydr. Polym. 2018, 180, 168–174. [Google Scholar] [CrossRef] [PubMed]
- Lu, J.; Chen, Y.; Ding, M.; Fan, X.; Hu, J.; Chen, Y.; Li, J.; Li, Z.; Liu, W. A 4arm-PEG macromolecule crosslinked chitosan hydrogels as antibacterial wound dressing. Carbohydr. Polym. 2022, 277, 118871. [Google Scholar] [CrossRef] [PubMed]
- Deng, P.; Yao, L.; Chen, J.; Tang, Z.; Zhou, J. Chitosan-based hydrogels with injectable, self-healing and antibacterial properties for wound healing. Carbohydr. Polym. 2022, 276, 118718. [Google Scholar] [CrossRef] [PubMed]
- Wang, X.; Song, R.; Johnson, M.; Sigen, A.; He, Z.; Lara-Sáez, I.; Xu, Q.; Wang, W.; Milne, C.; Wang, X. An Injectable Chitosan-Based Self-Healable Hydrogel System as an Antibacterial Wound Dressing. Materials 2021, 14, 5956. [Google Scholar] [CrossRef] [PubMed]
- Liu, J.; Jiang, W.; Xu, Q.; Zheng, Y. Progress in Antibacterial Hydrogel Dressing. Gels 2022, 8, 503. [Google Scholar] [CrossRef]
- Crivello, G.; Orlandini, G.; Morena, A.G.; Torchio, A.; Mattu, C.; Boffito, M.; Tzanov, T.; Ciardelli, G. Lignin-Cobalt Nano-Enabled Poly(pseudo)rotaxane Supramolecular Hydrogel for Treating Chronic Wounds. Pharmaceutics 2023, 15, 1717. [Google Scholar] [CrossRef]
- Aldakheel, F.M.; Mohsen, D.; El Sayed, M.M.; Alawam, K.A.; Binshaya, A.S.; Alduraywish, S.A. Silver Nanoparticles Loaded on Chitosan-g-PVA Hydrogel for the Wound-Healing Applications. Molecules. 2023, 28, 3241. [Google Scholar] [CrossRef]
- Zhang, J.J.; Tan, W.Q.; Li, Q.; Liu, X.R.; Guo, Z.Y. Preparation of cross-linked chitosan quaternary ammonium salt hydrogel films loading drug of gentamicin sulfate for antibacterial wound dressing. Mar. Drugs 2021, 19, 479. [Google Scholar] [CrossRef]
- Liao, C.H.; Chen, C.S.; Chen, Y.C.; Jiang, N.E.; Farn, J.C.; Shen, Y.S.; Hsu, M.L.; Chang, C.H. Vancomycin-loaded oxidized hyaluronic acid and adipic acid dihydrazide hydrogel: Bio-compatibility, drug release, antimicrobial activity, and biofilm model. J. Microbiol. Immunol. 2020, 53, 525–531. [Google Scholar] [CrossRef] [PubMed]
- Yan, D.; Li, Y.; Liu, Y.; Li, N.; Zhang, X.; Yan, C. Antimicrobial Properties of Chitosan and Chitosan Derivatives in the Treatment of Enteric Infections. Molecules 2021, 26, 7136. [Google Scholar] [CrossRef]
- Yilmaz Atay, H. Antibacterial Activity of Chitosan- Based Systems. Functional Chitosan 2020, 23, 457–489. [Google Scholar]
- Celesti, C.; Iannazzo, D.; Espro, C.; Visco, A.; Legnani, L.; Veltri, L.; Visalli, G.; Di Pietro, A.; Bottino, P.; Chiacchio, M.A. Chitosan/POSS Hybrid Hydrogels for Bone Tissue Engineering. Materials 2022, 15, 8208. [Google Scholar] [CrossRef] [PubMed]
- Kozusko, S.D.; Riccio, C.; Goulart, M.; Bumgardner, J.; Jing, X.L.; Konofaos, P. Chitosan as a Bone Scaffold Biomaterial. J. Craniofac. Surg. 2018, 29, 1788–1793. [Google Scholar] [CrossRef]
- Shi, W.; Zhang, X.; Bian, L.; Dai, Y.; Wang, Z.; Zhou, Y.; Yu, S.; Zhang, Z.; Zhao, P.; Tang, H.; et al. Alendronate crosslinked chitosan/polycaprolactone scaffold for bone defects repairing. Int. J. Biol. Macromol. 2022, 204, 441–456. [Google Scholar] [CrossRef]
- Costa-Pinto, A.R.; Lemos, A.L.; Tavaria, F.K.; Pintado, M. Chitosan and Hydroxyapatite Based Biomaterials to Circumvent Periprosthetic Joint Infections. Materials 2021, 14, 804. [Google Scholar] [CrossRef] [PubMed]
- Fasiku, V.O.; Omolo, C.A.; Devnarain, N.; Ibrahim, U.H.; Rambharose, S.; Faya, M.; Mocktar, C.; Singh, S.D.; Govender, T. Chitosan-Based Hydrogel for the Dual Delivery of Antimicrobial Agents against Bacterial Methicillin-Resistant Staphylococcus aureus Biofilm-Infected Wounds. ACS Omega 2021, 6, 21994–22010. [Google Scholar] [CrossRef]
- Chen, H.; Cheng, J.; Ran, L.; Yu, K.; Lu, B.; Lan, G.; Dai, F.; Lu, F. An Injectable Self-Healing Hydrogel with Adhesive and Antibacterial Properties Effectively Promotes Wound Healing. Carbohydr. Polym. 2018, 201, 522–531. [Google Scholar] [CrossRef]
- Huang, S.; Chen, H.J.; Deng, Y.P.; You, X.H.; Fang, Q.H.; Lin, M. Preparation of Novel Stable Microbicidal Hydrogel Films as Potential Wound Dressing. Polym. Degrad. Stab. 2020, 181, 109349. [Google Scholar] [CrossRef]
- Lo, W.H.; Deng, F.S.; Chang, C.J.; Lin, C.H. Synergistic Antifungal Activity of Chitosan with Fluconazole against Candida albicans, Candida tropicalis, and Fluconazole-Resistant Strains. Molecules 2020, 25, 5114. [Google Scholar] [CrossRef] [PubMed]
- Iannazzo, D.; Pistone, A.; Salamò, M.G.S. Hybrid Ceramic/Polymer Composites for Bone Tissue Regeneration. Hybrid Polym. Compos. Mater. 2017, 1, 125–155. [Google Scholar]
- Du, C.; Huang, W. Progress and Prospects of Nanocomposite Hydrogels in Bone Tissue Engineering. Nanocomposites 2022, 8, 102–124. [Google Scholar] [CrossRef]
- Rodríguez-Vázquez, M.; Vega-Ruiz, B.; Ramos-Zúñiga, R.; Saldaña-Koppel, D.A.; Quiñones-Olvera, L.F. Chitosan and Its Potential Use as a Scaffold for Tissue Engineering in Regenerative Medicine. Biomed. Res. Int. 2015, 2015, 821279. [Google Scholar] [CrossRef]
- Gao, S.; Tang, G.; Hua, D.; Xiong, R.; Han, J.; Jiang, S.; Zhang, Q.; Huang, C. Stimuli-Responsive Bio-Based Polymeric Systems and Their Applications. J. Mater. Chem. B 2019, 7, 709–729. [Google Scholar] [CrossRef] [PubMed]
- Legnani, L.; Iannazzo, D.; Pistone, A.; Celesti, C.; Giofrè, S.; Romeo, R.; Di Pietro, A.; Visalli, G.; Fresta, M.; Bottino, P.; et al. Functionalized polyhedral oligosilsesquioxane (POSS) based composites for bone tissue engineering: Synthesis, computational and biological studies. RSC Adv. 2020, 10, 11325–11334. [Google Scholar] [CrossRef] [PubMed]
- Croisier, F.; Jérôme, C. Chitosan-Based Biomaterials for Tissue Engineering. Eur. Polym. J. 2013, 49, 780–792. [Google Scholar] [CrossRef]
- Brun, V.; Guillaume, C.; Mechiche Alami, S.; Josse, J.; Jing, J.; Draux, F.; Bouthors, S.; Laurent-Maquin, D.; Gangloff, S.C.; Kerdjoudj, H.; et al. Chitosan/hydroxyapatite hybrid scaffold for bone tissue engineering. Biomed. Mater. Eng. 2014, 24, 63–73. [Google Scholar] [CrossRef]
- Logithkumar, R.; Keshavnarayan, A.; Dhivya, S.; Chawla, A.; Saravanan, S.; Selvamurugan, N. A Review of Chitosan and Its Derivatives in Bone Tissue Engineering. Carbohydr. Polym. 2016, 151, 172–188. [Google Scholar] [CrossRef]
- Pistone, A.; Iannazzo, D.; Celesti, C.; Piperopoulos, E.; Ashok, D.; Cembran, A.; Tricoli, A.; Nisbet, D. Engineering of Chitosan-Hydroxyapatite-Magnetite Hierarchical Scaffolds for Guided Bone Growth. Materials 2019, 12, 2321. [Google Scholar] [CrossRef]
- Yu, Y.; Bacsik, Z.; Edén, M. Contrasting In Vitro Apatite Growth from Bioactive Glass Surfaces with that of Spontaneous Precipitation. Materials 2018, 11, 1690. [Google Scholar] [CrossRef] [PubMed]
- Cordes, D.B.; Lickiss, P.D.; Rataboul, F. Recent developments in the chemistry of cubic polyhedral oligosilsesquioxanes. Chem. Rev. 2010, 110, 2081–2173. [Google Scholar] [CrossRef] [PubMed]
- Curotto, E.; Aros, F. Quantitative Determination of Chitosan and the Percentage of Free Amino Groups. Anal. Biochem. 1993, 211, 240–241. [Google Scholar] [CrossRef] [PubMed]
- Li, N.; Luo, H.K.; Chen, A.X.; Tan, J.P.K.; Yang, C.; Ang, M.J.Y.; Zeng, H.; Yang, Y.Y. Guanidinium-Perfunctionalized Polyhedral Oligomeric Silsesquioxanes as Highly Potent Antimicrobials against Planktonic Microbes, Biofilms, and Coronavirus. ACS Appl. Mater. Interfaces 2023, 15, 354–363. [Google Scholar] [CrossRef] [PubMed]
- Zanane, C.; Mitro, S.; Mazigh, D.; Lekchiri, S.; Hakim, T.; El Louali, M.; Latrache, H.; Zahir, H. Characterization of Streptomyces Cell Surface by the Microbial Adhesion to Solvents Method. Int. J. Microbiol. 2023, 2023, 8841509. [Google Scholar] [CrossRef] [PubMed]
- Spanò, A.; Laganà, P.; Visalli, G.; Maugeri, T.L.; Gugliandolo, C. In Vitro Antibiofilm Activity of an Exopolysaccharide from the Marine Thermophilic Bacillus licheniformis T14. Curr. Microbiol. 2016, 72, 518–528. [Google Scholar] [CrossRef] [PubMed]
- Peters, A.; Schmid, M.N.; Parneix, P.; Lebowitz, D.; de Kraker, M.; Sauser, J.; Zingg, W.; Pittet, D. Impact of environmental hygiene interventions on healthcare-associated infections and patient colonization: A systematic review. Antimicrob. Resist. Infect. Control 2022, 11, 38. [Google Scholar] [CrossRef]
- Yang, K.; Han, Q.; Chen, B.; Zheng, Y.; Zhang, K.; Li, Q.; Wang, J. Antimicrobial hydrogels: Promising materials for medical application. Int. J. Nanomed. 2018, 13, 2217–2263. [Google Scholar] [CrossRef]
- Dutra, G.V.S.; Neto, W.S.; Dutra, J.P.S.; Machado, F. Implantable Medical Devices and Tissue Engineering: An Overview of Manufacturing Processes and the Use of Polymeric Matrices for Manufacturing and Coating their Surfaces. Curr. Med. Chem. 2020, 27, 1580–1599. [Google Scholar] [CrossRef]
- Di Giuseppe, G.; Mitidieri, M.; Cantore, F.; Pelullo, C.P.; Pavia, M. Community-Acquired and Healthcare-Associated Sepsis: Characteristics and in-Hospital Mortality in Italy. Antibiotics 2020, 9, 263. [Google Scholar] [CrossRef]
- Shankar, S.; Rhim, J.W. Preparation of sulfur nanoparticle-incorporated antimicrobial chitosan films. Food Hydrocoll. 2018, 82, 116–123. [Google Scholar] [CrossRef]
- Duan, C.; Meng, X.; Meng, J.; Khan, M.I.H.; Dai, L.; Khan, A.; An, X.; Zhang, J.; Huq, T.; Ni, Y. Chitosan as A Preservative for Fruits and Vegetables: A Review on Chemistry and Antimicrobial Properties. J. Bioresour. Bioprod. 2019, 4, 11–21. [Google Scholar] [CrossRef]
- Ardean, C.; Davidescu, C.M.; Nemeş, N.S.; Negrea, A.; Ciopec, M.; Duteanu, N.; Negrea, P.; Duda-Seiman, D.; Musta, V. Factors Influencing the Antibacterial Activity of Chitosan and Chitosan Modified by Functionalization. Int. J. Mol. Sci. 2021, 22, 7449. [Google Scholar] [CrossRef] [PubMed]
- Sabet, S.M.; Mahfuz, H.; Terentis, A.C.; Hashemi, J.; Boesl, B. A facile approach to the synthesis of multi-walled carbon nanotube-polyhedral oligomeric silsesquioxane (POSS) nanohybrids. Mater. Lett. 2016, 168, 9–12. [Google Scholar] [CrossRef]
- Banerjee, S.; Kataoka, S.; Takahashi, T.; Kamimura, Y.; Suzuki, K.; Sato, K.; Endo, A. Controlled formation of ordered coordination polymeric networks using silsesquioxane building blocks. Dalton Trans. 2016, 45, 17082–17086. [Google Scholar] [CrossRef]
- Chew, S.L.; Wang, K.; Chai, S.P.; Goh, K.L. Elasticity, Thermal Stability and Bioactivity of Polyhedral Oligomeric Silsesquioxanes Reinforced Chitosan-Based Microfibres. J. Mater. Sci. Mater. Med. 2011, 22, 1365–1374. [Google Scholar] [CrossRef] [PubMed]
- Tamburaci, S.; Tihminlioglu, F. Novel Poss Reinforced Chitosan Composite Membranes for Guided Bone Tissue Regeneration. J. Mater. Sci. Mater. Med. 2018, 29, 1–14. [Google Scholar] [CrossRef]
- Ha, Y.M.; Amna, T.; Kim, M.H.; Kim, H.C.; Hassan, M.S.; Khil, M.S. Novel Silicificated PVAc/POSS Composite Nanofibrous Mat via Facile Electrospinning Technique: Potential Scaffold for Hard Tissue Engineering. Colloids Surf. B Biointerfaces 2013, 102, 795–802. [Google Scholar] [CrossRef]
- Tamburaci, S.; Tihminlioglu, F. Chitosan-Hybrid Poss Nanocomposites for Bone Regeneration: The Effect of Poss Nanocage on Surface, Morphology, Structure and in Vitro Bioactivity. Int. J. Biol. Macromol. 2020, 142, 643–657. [Google Scholar] [CrossRef]
- Yu, J.; Liu, Z.; Shen, J.; Lu, C.; Hu, X.; Dong, N.; Yang, G.; Chen, Z.; Nie, J. Biodegradable Inorganic–Organic POSS–PEG Hybrid Hydrogels as Scaffolds for Tissue Engineering. Macromol. Mater. Eng. 2017, 302, 1–11. [Google Scholar] [CrossRef]
- Xiang, Y.; Qi, X.; Cai, E.; Zhang, C.; Wang, J.; Lan, Y.; Deng, H.; Shen, J.; Hu, R. Highly efficient bacteria-infected diabetic wound healing employing a melanin-reinforced biopolymer hydrogel. Chem. Eng. J. 2023, 460, 141852. [Google Scholar] [CrossRef]
- Qi, X.; Xiang, Y.; Cai, E.; You, S.; Gao, T.; Lan, Y.; Deng, H.; Li, Z.P.; Hu, R.; Shen, J. All-in-one: Harnessing multifunctional injectable natural hydrogels for ordered therapy of bacteria-infected diabetic wounds. Chem. Eng. J. 2022, 439, 135691. [Google Scholar] [CrossRef]
- Donelli, G.; Vuotto, C. Biofilm-based infections in long-term care facilities. Future Microbiol. 2014, 9, 175–188. [Google Scholar] [CrossRef] [PubMed]
- Bowler, P.; Murphy, C.; Wolcott, R. Biofilm exacerbates antibiotic resistance: Is this a current oversight in antimicrobial stewardship? Antimicrob. Resist. Infect. Control 2020, 9, 162. [Google Scholar] [CrossRef]

| MSSA (7) | MRSA (6) | MSSE (4) | MRSE (9) | VSE (5) | VRE (7) | Non-MDR PSEAER (3) | MDR PSEAER (3) | |
|---|---|---|---|---|---|---|---|---|
| Amikacin | -- | -- | -- | -- | -- | -- | 0% | 0% |
| Amoxicillin Clavulanate | -- | -- | -- | -- | 50% | 100% | -- | -- |
| Ampicillin | -- | -- | -- | -- | 50% | 100% | -- | -- |
| Ampicillin/Sulbactam | -- | -- | -- | -- | 50% | 100% | -- | -- |
| Benzylpenicillin | 71.4% | 85.7% | -- | -- | -- | -- | -- | -- |
| Cefepime | -- | -- | -- | -- | -- | -- | 0% | 50% |
| Cefoxitin | -- | 100% | -- | -- | -- | -- | -- | -- |
| Ceftaroline | 0% | 0% | -- | -- | -- | -- | -- | -- |
| Ceftazidime | -- | -- | -- | -- | -- | -- | 0% | 50% |
| Ceftazidime/Avibactam | -- | -- | -- | -- | -- | -- | 0% | 0% |
| Ciprofloxacin | -- | -- | -- | -- | 50% | 100% | 33.3% | 0% |
| Clindamycin | 28.6% | 71.4% | 0% | 55.6% | -- | -- | -- | -- |
| Colistin | -- | -- | -- | -- | -- | -- | 0% | 0% |
| Co-trimoxazole | 0% | 0% | 0% | 0% | -- | -- | -- | -- |
| Daptomycin | 0% | 0% | 0% | 0% | -- | -- | -- | -- |
| Erythromycin | 28.6% | 71.4% | 50% | 77.8% | -- | -- | -- | -- |
| Fosfomycin | -- | -- | -- | -- | -- | -- | 33.3% | -- |
| Fusidic acid | 14.3% | 0% | 25% | 66.7% | -- | -- | -- | -- |
| Gentamicin | 0% | 0% | 50% | 66.7% | 0% | 71.4% | 0% | 0% |
| Imipenem | -- | -- | -- | -- | 50% | 100% | 0% | 100% |
| Kanamycin | -- | -- | -- | -- | 50% | 71.4% | -- | -- |
| Levofloxacin | 0% | 28.6% | 0% | 88.9% | 50% | 100% | -- | -- |
| Linezolid | 0% | 0% | 0% | 11.1% | 0% | 0% | -- | -- |
| Meropenem | -- | -- | -- | -- | -- | -- | 0% | 0% |
| Mupirocin | 0% | 0% | -- | -- | -- | -- | -- | -- |
| Oxacillin | 0% | 100% | 0% | 100% | -- | -- | -- | -- |
| Piperacillin/Tazobactam | -- | -- | -- | -- | -- | -- | 0% | 50% |
| Quinupristin/Dalfopristin | -- | -- | -- | -- | 25% | 0% | -- | -- |
| Rifampicin | 0% | 0% | 0% | 11.1% | -- | -- | -- | -- |
| Streptomycin | -- | -- | -- | -- | 50% | 71.4% | -- | -- |
| Teicoplanin | 0% | 0% | 0% | 44.4% | 0% | 100% | -- | -- |
| Tetracycline | 0% | 14.3% | 75% | 22.2% | -- | -- | -- | -- |
| Tigecycline | 0% | 0% | 0% | 0% | 0% | 14.3% | -- | -- |
| Tobramycin | -- | -- | -- | -- | -- | -- | 0% | 0% |
| Vancomycin | 0% | 0% | 0% | 0% | 0% | 100% | -- | -- |
| Average Value | 8.4% | 26.2% | 14.3% | 38.9% | 30.4% | 73.5% | 5.5% | 22.7% |
Disclaimer/Publisher’s Note: The statements, opinions and data contained in all publications are solely those of the individual author(s) and contributor(s) and not of MDPI and/or the editor(s). MDPI and/or the editor(s) disclaim responsibility for any injury to people or property resulting from any ideas, methods, instructions or products referred to in the content. |
© 2023 by the authors. Licensee MDPI, Basel, Switzerland. This article is an open access article distributed under the terms and conditions of the Creative Commons Attribution (CC BY) license (https://creativecommons.org/licenses/by/4.0/).
Share and Cite
Laganà, A.; Facciolà, A.; Iannazzo, D.; Celesti, C.; Polimeni, E.; Biondo, C.; Di Pietro, A.; Visalli, G. Promising Materials in the Fight against Healthcare-Associated Infections: Antibacterial Properties of Chitosan-Polyhedral Oligomeric Silsesquioxanes Hybrid Hydrogels. J. Funct. Biomater. 2023, 14, 428. https://doi.org/10.3390/jfb14080428
Laganà A, Facciolà A, Iannazzo D, Celesti C, Polimeni E, Biondo C, Di Pietro A, Visalli G. Promising Materials in the Fight against Healthcare-Associated Infections: Antibacterial Properties of Chitosan-Polyhedral Oligomeric Silsesquioxanes Hybrid Hydrogels. Journal of Functional Biomaterials. 2023; 14(8):428. https://doi.org/10.3390/jfb14080428
Chicago/Turabian StyleLaganà, Antonio, Alessio Facciolà, Daniela Iannazzo, Consuelo Celesti, Evelina Polimeni, Carmelo Biondo, Angela Di Pietro, and Giuseppa Visalli. 2023. "Promising Materials in the Fight against Healthcare-Associated Infections: Antibacterial Properties of Chitosan-Polyhedral Oligomeric Silsesquioxanes Hybrid Hydrogels" Journal of Functional Biomaterials 14, no. 8: 428. https://doi.org/10.3390/jfb14080428
APA StyleLaganà, A., Facciolà, A., Iannazzo, D., Celesti, C., Polimeni, E., Biondo, C., Di Pietro, A., & Visalli, G. (2023). Promising Materials in the Fight against Healthcare-Associated Infections: Antibacterial Properties of Chitosan-Polyhedral Oligomeric Silsesquioxanes Hybrid Hydrogels. Journal of Functional Biomaterials, 14(8), 428. https://doi.org/10.3390/jfb14080428

